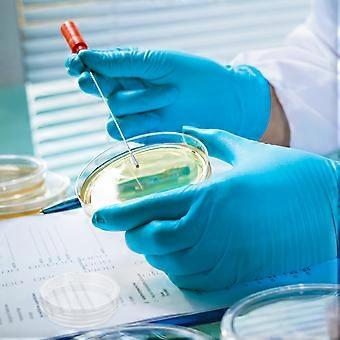

30pcs Plastic Petri Dish with Lid Tissue Culture Plate Science Experiment Supplies Transparent35mm)
ÜCRETSİZ Kargo
30pcs Plastic Petri Dish with Lid Tissue Culture Plate Science Experiment Supplies Transparent35mm)
- Marka: Unbranded

30pcs Plastic Petri Dish with Lid Tissue Culture Plate Science Experiment Supplies Transparent35mm)
- Marka: Unbranded
| Önerilen Perakende Fiyatı: | |
| Fiyat: | |
| Kazancınız: | ₺1.680,00 (80%) |
Stokta var
Biz aşağıdaki ödeme yöntemlerini kabul ediyoruz
Tanım
- Marka: Unbranded
- Kategoriye Göre: Petri Kapları
-
Renk: Transparent
-
Beden: 3.50X3.50X1.50CM
- Fruugo Kimliği: 306779899-687166424
- EAN: 8162581179154
Ürün Güvenlik Bilgileri
Lütfen aşağıda özetlenen bu ürüne özel ürün güvenlik bilgilerine bakın.
Aşağıdaki bilgiler bu ürünü satan bağımsız üçüncü taraf perakendeci tarafından sağlanmaktadır.
Ürün Güvenlik Etiketleri

Teslimat ve İade
2 gün içinde kargoya verilir
-
STANDARD: ÜCRETSİZ - Arasında teslimat Per 06 Kasım 2025–Per 13 Kasım 2025 - ÜCRETSİZ
Kargo çıkış noktası Çin.
Sipariş ettiğiniz ürünlerin size bütün ve belirttiğiniz özelliklere göre teslim edilmesi için elimizden gelenin en iyisini yapıyoruz. Fakat, bütün gelmeyen veya siparişiniz ettiğinizden farklı çıkan bir ürünün elinize ulaşması ya da siparişinizden başka bir sebepten ötürü memnun kalmamanız durumunda, siparişi veya siparişe dahil ürünlerden herhangi birini iade edebilir ve ürünler için tam para iadesi alabilirsiniz. Tam iade politikasını görüntüle
Ürün Uyumluluk Ayrıntıları
Lütfen aşağıda özetlenen bu ürüne özel uyumluluk bilgilerine bakın.
Aşağıdaki bilgiler bu ürünü satan bağımsız üçüncü taraf perakendeci tarafından sağlanmaktadır.
Üretici:
Aşağıdaki bilgiler, Fruugo tarafında satılan bahsi geçen ürünün üreticisinin irtibat bilgilerini ortaya koymaktadır.
- Shenzhen Wenwen Guyue Technology Co., Ltd.
- Shenzhen Wenwen Guyue Technology Co., Ltd.
- C336A2, Block BC, No. 1021 Houhai Avenue, Yuyi Community, Shekou Street, Nanshan District, Shenzhen
- Shenzhen
- CN
- 518000
- diseaseine@126.com
- 19065101846
AB sınırları içerisindeki Sorumlu Kişi:
Aşağıdaki bilgiler AB sınırları içerisindeki Sorumlu Kişi’nin irtibat bilgilerini ortaya koymaktadır. Sorumlu kişi AB içerisinde konumlu olan atanmış iktisadi işlemcidir, Avrupa Birliği içerisinde satılan bahsi geçen ürün ile ilgili uygunluk yükümlülüklerinden sorumludur.
- GAVIMOSA CONSULTORIA, SOCIEDAD LIMITADA
- GAVIMOSA CONSULTORIA, SOCIEDAD LIMITADA
- CASTELLANA 9144, 28046 Madrid
- Madrid
- ES
- 28046
- compliance.gavimosa@outlook.com
- +34 696313170